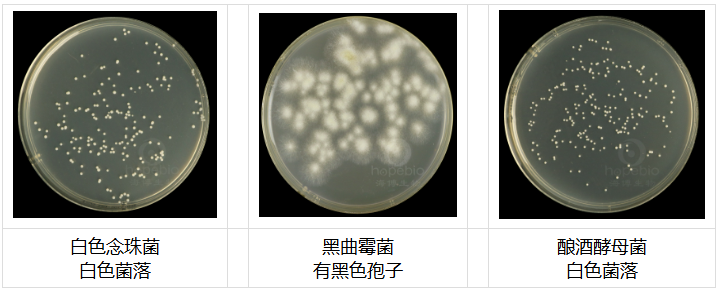
63858347.png

电话:13001385296
QQ:2105131983
办公:天津市武清区京滨工业园
产品名称:马铃薯葡萄糖琼脂培养基(PDA)
产品货号:HB0233-12
生产厂家:青岛海博
产品规格:250g / 瓶
保存条件:应储存于阴凉干燥处避光保存,防止受潮、结块和暴晒。
保质期:三年
产品用途:用于霉菌、酵母菌计数(中国药典)。
产品成分:每升含马铃薯浸出粉12.0g,葡萄糖20.0g,琼脂14.0g,pH值5.6±0.2(25℃)。
检验原理:马铃薯浸出粉有助于各种霉菌和酵母菌的生长;葡萄糖提供能源;琼脂是培养基的凝固剂。
使用方法:称取本品46.0g,加入1000ml纯化水中,115℃高压灭菌15分钟,备用。灭菌好的培养基仅可重复加热熔化一次。
注:培养基中使用的马铃薯浸粉中含有较多淀粉类成分,灭菌后的培养基稍浑浊,可能出现少量白色沉淀,摇匀倒平板即可。灭菌前加热煮沸溶解培养基再进行灭菌不易出现沉淀。
产品特点
质量控制
不同真菌在马铃薯葡萄糖琼脂(PDA)上的生长特征:
马铃薯葡萄糖琼脂(PDA)(中国药典)微生物灵敏度试验:
按标签用法制备培养基,接种以下质控菌株,放置20-25℃需氧培养48-72小时。
注:回收率计算时,用SDA 琼脂做对照培养基。
